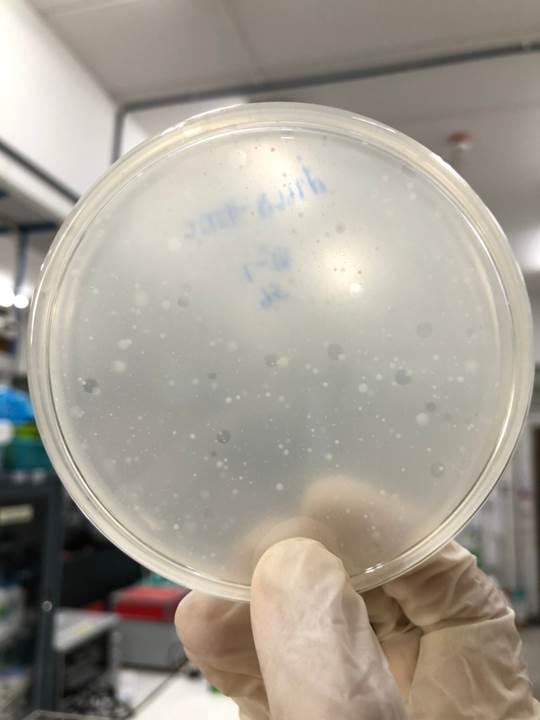
การเพาะเชื้อไวรัสชี้แนะในห้อง Lab

หนึ่งในวิธีการที่มีประสิทธิภาพในการควบคุมการแพร่ระบาดของโรคที่ติดต่อได้ง่ายและรวดเร็วในแต่ละชุมชนหรือแต่ละพื้นที่ ก็คือการเก็บตัวอย่างน้ำจากแหล่งน้ำเสียในชุมชน มาทำการตรวจวิเคราะห์หาปริมาณเชื้อก่อโรคเหล่านั้นด้วยวิธีการที่ถูกต้องและได้มาตรฐานอย่างเป็นระบบและต่อเนื่อง
ดังนั้น จึงเป็นที่มาของ “ระบบการเตือนภัยและคาดการณ์การระบาดของโรคโควิด-19 ด้วยการตรวจวิเคราะห์การปนเปื้อนของเชื้อไวรัส SARS-CoV-2 ในน้ำเสียชุมชน” (Early Warning and Predicting System for COVID-19 Outbreaks Using Wastewater-based Epidemiology) ซึ่งเป็นผลงานวิจัยร่วมของทีมวิจัย 9 ท่าน ประกอบด้วย 1) ดร.ขวัญรวี สิริกาญจน สถาบันวิจัยจุฬาภรณ์ 2) ผศ. ดร.สุรพงษ์ รัตนกุล มหาวิทยาลัยเทคโนโลยีพระจอมเกล้าธนบุรี 3) ดร.จตุวัฒน์ แสงสานนท์ จุฬาลงกรณ์มหาวิทยาลัย 4) ผศ. ดร.ประเสริฐ มากแก้ว มหาวิทยาลัยวลัยลักษณ์ 5) ผศ.นพดล ปรีชา มหาวิทยาลัยวลัยลักษณ์ 6) ศ.เกียรติคุณ ดร.ศกรณ์ มงคลสุข สถาบันวิจัยจุฬาภรณ์ 7) ศ.นพ.ยง ภู่วรวรรณ คณะแพทยศาสตร์ จุฬาลงกรณ์มหาวิทยาลัย 8) ดร.พญ.ศมน วรรณลภากร คณะแพทยศาสตร์ จุฬาลงกรณ์มหาวิทยาลัย และ9) มนทกานต์ ศรีสังข์ สถาบันวิจัยจุฬาภรณ์

ผศ.ดร.สุรพงษ์ รัตนกุล อาจารย์ประจำภาควิชาวิศวกรรมสิ่งแวดล้อม คณะวิศวกรรมศาสตร์ มหาวิทยาลัยเทคโนโลยีพระจอมเกล้าธนบุรี (มจธ.) ในฐานะผู้ร่วมวิจัย กล่าวว่า จุดเริ่มต้นของงานวิจัยนี้เกิดขึ้นเมื่อราวกลางปี 2564 ซึ่งเป็นช่วงที่โรคติดเชื้อ COVID-19 เกิดการระบาดอย่างหนักทั่วโลกนั้น ทางทีมวิจัยที่มีจุดแข็งด้านการทำงานกับเชื้อก่อโรคในน้ำ จึงได้เริ่มต้นพัฒนาวิธีการตรวจวัดเชื้อ COVID-19 การวิเคราะห์และแปรผล เพื่อนำมาช่วยในการจัดทำระบบตรวจการปนเปื้อนของเชื้อโควิดจากแหล่งน้ำเสียของชุมชนในเขตกรุงเทพมหานคร

“เมื่อร่างกายได้รับเชื้อ COVID-19 ทั้งในระยะที่ป่วยหรือระยะที่ยังไม่แสดงอาการ จะพบเชื้อโควิดปนเปื้อนผ่านอุจจาระ ปัสสาวะ และสารคัดหลั่ง ที่สุดท้ายเชื้อCOVID-19 ก็จะไปอยู่ในแหล่งน้ำเสียหรือระบบบำบัดน้ำเสียของชุมชน งานวิจัยของเราในช่วงแรก (ม.ค. 65 – เม.ย. 65) คือ การลงพื้นที่เก็บตัวอย่างน้ำเสียในชุมชนต่างๆ จากระบบบำบัดน้ำเสียหลัก 19 แห่ง ของกรุงเทพมหานคร มาตรวจจวัดปริมาณเชื้อ COVID ด้วยวิธีการตรวจวัดที่ได้พัฒนาขึ้นมา และนำค่าปริมาณของเชื้อ COVID-19 ในน้ำเสียจากโรงบำบัดน้ำเสียแต่ละแห่ง มาวิเคราะห์เพื่อคาดการณ์หาว่าพื้นที่ใดจะมีแนวโน้มที่จำนวนผู้ป่วยโรคติดเชื้อ COVID-19 เพิ่มมากขึ้น” ผศ.ดร.สุรพงษ์ กล่าว

จุดเด่นของระบบที่ทีมวิจัยพัฒนาเป็นการนำหลักการระบาดวิทยาของน้ำเสียแต่เดิมที่ใช้สำหรับตรวจวัดปริมาณการใช้สารเสพติดในชุมชนมาประยุกต์ใช้ โดยมีการการออกแบบพัฒนาขั้นตอน หรือวิธีการตรวจวัดน้ำเสียที่จำเพาะเข้าไปตรวจจับยีนของเชื้อไวรัส COVID-19 ที่ใช้เวลาเพียงประมาณ 8 ชั่วโมงก็ทราบผลได้ รวมถึงปริมาณของเชื้อCOVID-19 ที่ตรวจเจอก็สามารถนำมาวิเคราะห์และประมาณการจำนวนผู้ติดเชื้อทั้งที่แสดงและไม่แสดงอาการได้ด้วย
“วิธีการที่ทางทีมวิจัยของเราพัฒนาขึ้น นอกจากจะสามารถบอกได้ว่า พบหรือไม่พบเชื้อCOVID-19 แล้ว ยังสามารถช่วยทำนายการระบาดได้ล่วงหน้า 1-2 สัปดาห์ หรืออาจล่วงหน้าได้ถึง 3 สัปดาห์ในกรณีที่ตรวจพบเชื้อCOVID-19 ในน้ำเสียก่อนที่พื้นที่นั่นจะมีผู้แสดงอาการป่วยโรคCOVID-19 นอกจากนี้ตัวเลขของปริมาณเชื้อในน้ำเสีย ยังสามารถนำมาทำนายแนวโน้มจำนวนผู้ป่วยหรือบอกถึงปริมาณของคนที่จะติดเชื้อเพิ่มขึ้นได้อีกด้วย โดยยังสามารถทำการ Mapping แสดง Hot Spots ของจำนวนผู้ป่วยในแต่ละพื้นที่ภายใต้โรงบำบัดน้ำเสียของกรุงเทพมหานครแต่ละแห่งได้อย่างมีประสิทธิภาพ ซึ่งข้อมูลที่ได้จากการตรวจหาเชื้อโควิดจากน้ำเสียนี้ จะเป็นประโยชน์ให้กับหน่วยงานที่เกี่ยวข้อง เช่น กรมอนามัย หรือ กรมควบคุมโรค กระทรวงสาธารณสุข เป็นต้น รวมถึงสามารถเป็นข้อมูลที่ใช้ประกอบการตัดสินใจเพื่อการออกมาตรการหรือนโยบายในการควบคุมการระบาดที่จะเกิดขึ้นในชุมชนหรือพื้นที่นั้น ๆ ได้” ผศ.ดร.สุรพงษ์ กล่าว

หลังจากสิ้นสุดโครงการวิจัยในระยะแรก ทางทีมวิจัยได้วิเคราะห์ข้อมูลและดำเนินการวิจัยต่อในระยะที่สองโดยทำการศึกษาตรวจวัดเชื้อCOVID-19 จากตัวอย่างน้ำเสียจากโรงบำบัดน้ำเสียขนาดใหญ่ของ กทม. เพียง 4 แห่ง ซึ่งสามารถใช้เพื่อติดตามการระบาดของเชื้อโควิดในพื้นที่ที่ระบบบำบัดน้ำเสียของกรุงเทพมหานครครอบคลุมได้ โดยทีมวิจัยยังได้นำแนวทางปฏิบัตินี้ไปใช้กับการตรวจวัดเชื้อ COVID-19 ในน้ำเสียของจังหวัดภูเก็ต ในช่วงที่จังหวัดภูเก็ตเปิดรับนักท่องเที่ยวต่างประเทศใหม่ๆ ภายใต้โครงการ “ภูเก็ตแซนด์บ็อกซ์ (Phuket Sandbox)” เพื่อใช้ตรวจหา “เชื้อCOVID-19 สายพันธุ์ใหม่” ที่มีโอกาสนำเข้ามาพร้อมกับนักท่องเที่ยวจากทั่วโลก
จากผลสำเร็จที่ปรากฏผลเชิงรูปธรรม นอกจากจะทำให้ผลงานวิจัยชิ้นนี้ยังได้รับการตีพิมพ์ในวารสารวิชาการระดับนานาชาติเป็นที่ยอมรับทั้งในระดับนานาชาติและระดับชาติ 2 ฉบับด้วยกัน คือ 1. เรื่อง “SARS-CoV-2 RNA surveillance in large to small centralized wastewater treatment plants preceding the third COVID-19 resurgence in Bangkok, Thailand” ปี 2022 วารสารวิชาการ Science of The Total Environment และ 2. เรื่อง “Wastewater monitoring in tourist cities as potential sentinel sites for near real-time dynamics of imported SARS-CoV-2 variants” ปี 2023 วารสารวิชาการ Science of The Total Environment แล้ว ผลงานชิ้นนี้ยังได้รับรางวัลการวิจัยแห่งชาติ: รางวัลผลงานวิจัย ประจำปี 2567 รางวัลระดับดี สาขาวิทยาศาสตร์เคมีและเภสัช โดยสำนักงานการวิจัยแห่งชาติ (วช.) อีกด้วย
ปัจจุบัน ทีมวิจัยได้นำระบบฯ หรือเทคนิคการตรวจหาเชื้อไวรัส COVID SARS-CoV-2 ในน้ำเสียชุมชนนี้ ไปต่อยอดงานวิจัยที่ใช้ระบาดวิทยาในการตรวจหาเชื้ออื่นๆ เช่น “การตรวจวัดเชื้อแบคทีเรียดื้อยาปฏิชีวนะในน้ำเสีย” “การตรวจวัดเชื้อโรคอุบัติใหม่” และ “การควบคุมเชื้อก่อโรคอุบัติใหม่ในน้ำเพื่อควบคุมการแพร่ระบาด”
ทั้งนี้ เทคนิคและขั้นตอนการวิเคราะห์ได้ถูกบรรจุไว้ใน “คู่มือแนวทางการเฝ้าระวังการระบาดของโรคติดเชื้อไวรัสโคโรนา 2019 ด้วยน้ำเสีย” สามารถเข้าไปดูได้ที่เว็บไซต์กระทรวงสาธารณสุข